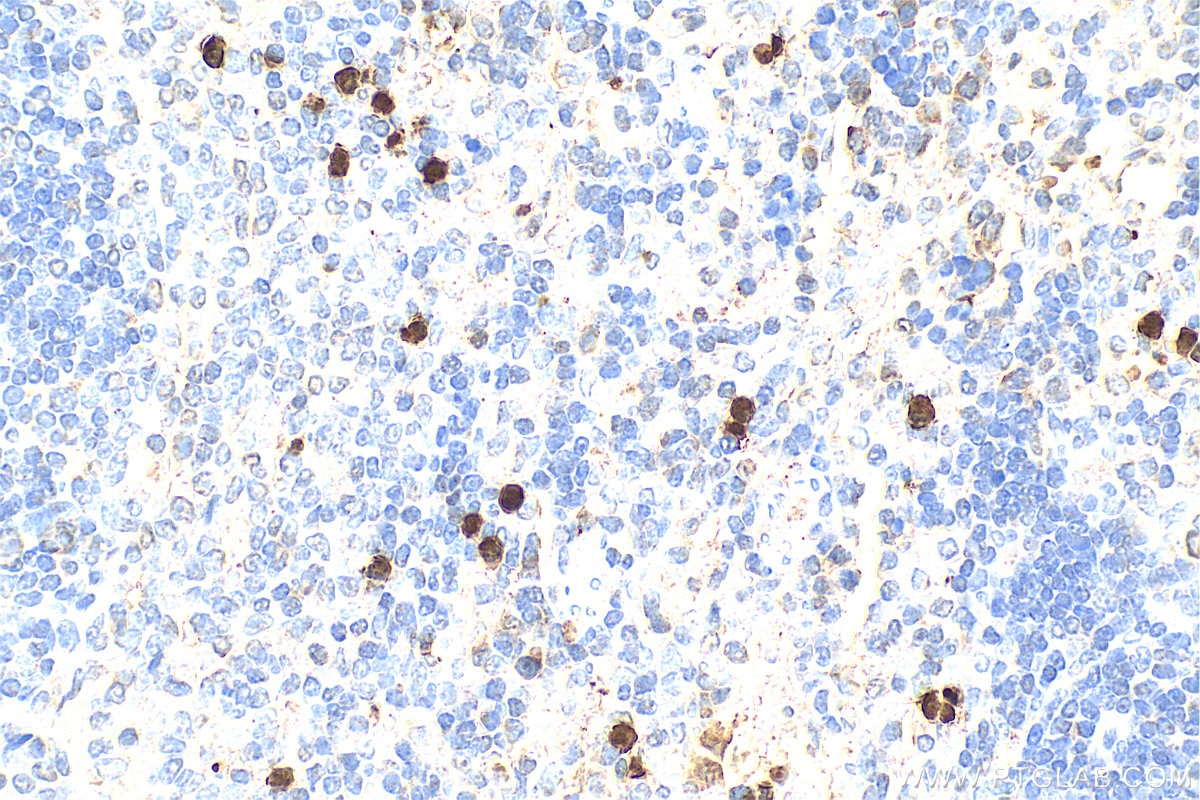
Immunohistochemistry (IHC) staining of rat spleen tissue using S100A8 Polyclonal antibody (15792-1-AP)

Tested Applications
| Positive WB detected in | HL-60 cells, A549 cells, COLO 320 cells, THP-1 cells, MCF-7 cells |
| Positive IP detected in | MCF-7 cells |
| Positive IHC detected in | mouse lung tissue, human stomach cancer tissue, rat spleen tissue Note: suggested antigen retrieval with TE buffer pH 9.0; (*) Alternatively, antigen retrieval may be performed with citrate buffer pH 6.0 |
| Positive IF-P detected in | mouse stomach tissue, mouse lung tissue, mouse spleen tissue |
| Positive IF/ICC detected in | THP-1 cells |
Recommended dilution
| Application | Dilution |
|---|---|
| Western Blot (WB) | WB : 1:500-1:2000 |
| Immunoprecipitation (IP) | IP : 0.5-4.0 ug for 1.0-3.0 mg of total protein lysate |
| Immunohistochemistry (IHC) | IHC : 1:50-1:500 |
| Immunofluorescence (IF)-P | IF-P : 1:50-1:500 |
| Immunofluorescence (IF)/ICC | IF/ICC : 1:200-1:800 |
| It is recommended that this reagent should be titrated in each testing system to obtain optimal results. | |
| Sample-dependent, Check data in validation data gallery. | |
Published Applications
| KD/KO | See 2 publications below |
| WB | See 29 publications below |
| IHC | See 15 publications below |
| IF | See 11 publications below |
Product Information
15792-1-AP targets S100A8 in WB, IHC, IF/ICC, IF-P, IP, ELISA applications and shows reactivity with human, mouse, rat samples.
| Tested Reactivity | human, mouse, rat |
| Cited Reactivity | human, mouse, rat |
| Host / Isotype | Rabbit / IgG |
| Class | Polyclonal |
| Type | Antibody |
| Immunogen |
CatNo: Ag8500 Product name: Recombinant human S100A8 protein Source: e coli.-derived, PGEX-4T Tag: GST Domain: 1-93 aa of BC005928 Sequence: MLTELEKALNSIIDVYHKYSLIKGNFHAVYRDDLKKLLETECPQYIRKKGADVWFKELDINTDGAVNFQEFLILVIKMGVAAHKKSHEESHKE Predict reactive species |
| Full Name | S100 calcium binding protein A8 |
| Calculated Molecular Weight | 93 aa, 11 kDa |
| Observed Molecular Weight | 11 kDa |
| GenBank Accession Number | BC005928 |
| Gene Symbol | S100A8 |
| Gene ID (NCBI) | 6279 |
| RRID | AB_10666315 |
| Conjugate | Unconjugated |
| Form | Liquid |
| Purification Method | Antigen affinity purification |
| UNIPROT ID | P05109 |
| Storage Buffer | PBS with 0.02% sodium azide and 50% glycerol, pH 7.3. |
| Storage Conditions | Store at -20°C. Stable for one year after shipment. Aliquoting is unnecessary for -20oC storage. 20ul sizes contain 0.1% BSA. |
Background Information
S100A8 is a member of the S100 family of proteins containing 2 EF-hand calcium-binding motifs. S100 proteins are localized in the cytoplasm and/or nucleus of a wide range of cells, and involved in the regulation of a number of cellular processes such as cell cycle progression and differentiation. S100 genes include at least 13 members which are located as a cluster on chromosome 1q21. This protein may function in the inhibition of casein kinase and as a cytokine. S100A8 may form homodimer or heterodimer with S100A9(16216873).
Protocols
| Product Specific Protocols | |
|---|---|
| IF protocol for S100A8 antibody 15792-1-AP | Download protocol |
| IHC protocol for S100A8 antibody 15792-1-AP | Download protocol |
| IP protocol for S100A8 antibody 15792-1-AP | Download protocol |
| WB protocol for S100A8 antibody 15792-1-AP | Download protocol |
| Standard Protocols | |
|---|---|
| Click here to view our Standard Protocols |
Publications
| Species | Application | Title |
|---|---|---|
Cell Rep Med Discovery of galectin-8 as an LILRB4 ligand driving M-MDSCs defines a class of antibodies to fight solid tumors | ||
Nat Commun S100A9-CXCL12 activation in BRCA1-mutant breast cancer promotes an immunosuppressive microenvironment associated with resistance to immunotherapy. | ||
Mol Ther Bulk and single-cell transcriptome profiling reveal the metabolic heterogeneity in human breast cancers.
| ||
Phytomedicine Geniposide via enema alleviates colitis by modulating intestinal flora and bile acid metabolites, inhibiting S100A8/S100A9/NF-κB, and promoting TGR5 inhibition of NLRP3 inflammasome |